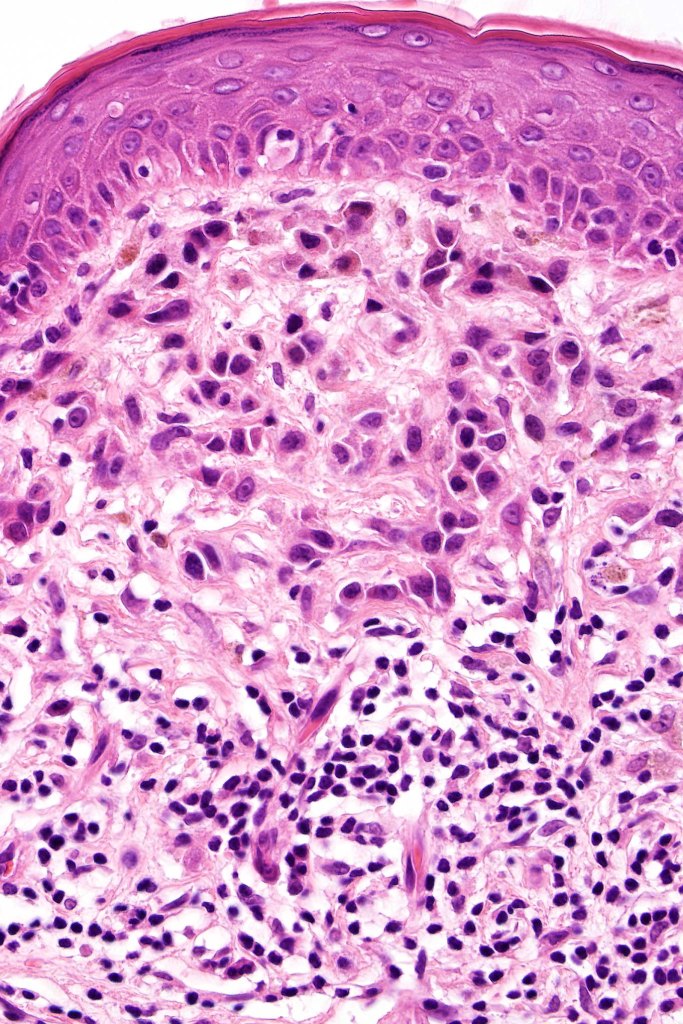
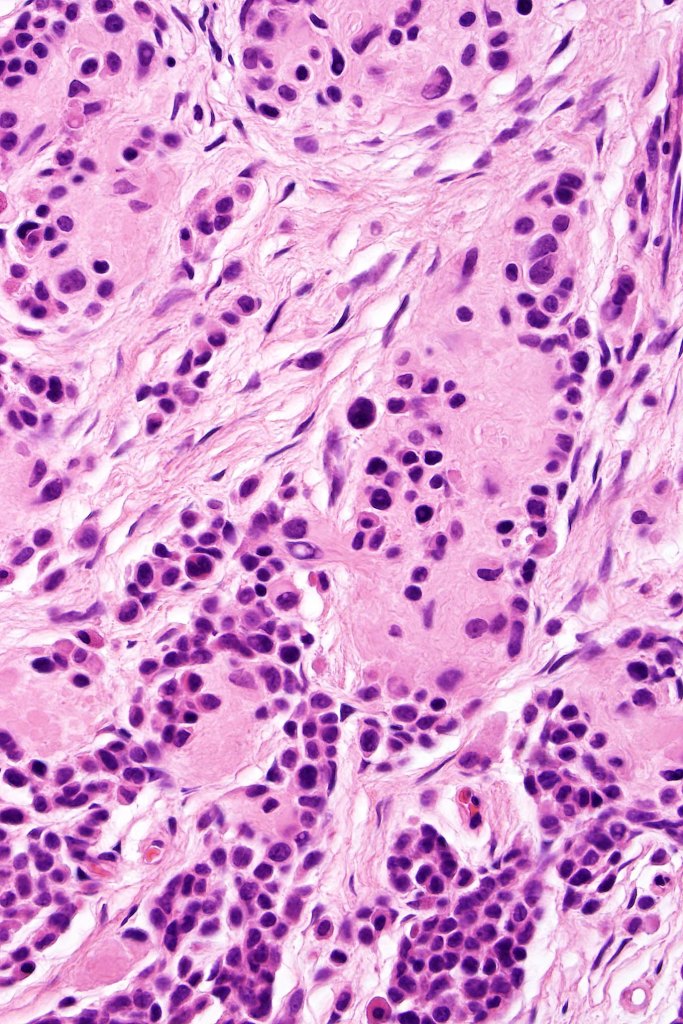
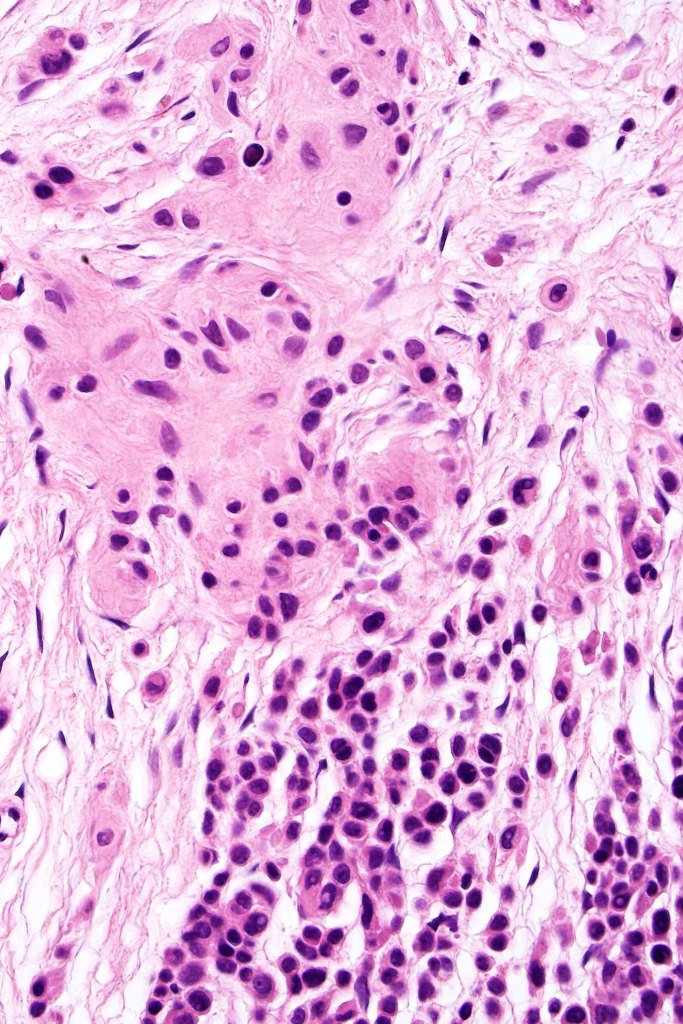

This is uncommon and presents clinically with a history of recent change in color of a common or less often congenital nevus causing concern for melanoma by the clinician. Some, but not all are probably deep penetrating and combined nevus variants. Others may represent follicular type-A cell nests. It is characterized by the presence of deep nest(s) of type -A nevus cells surrounded by & with overlying type-B nevus cells.

Leave a comment